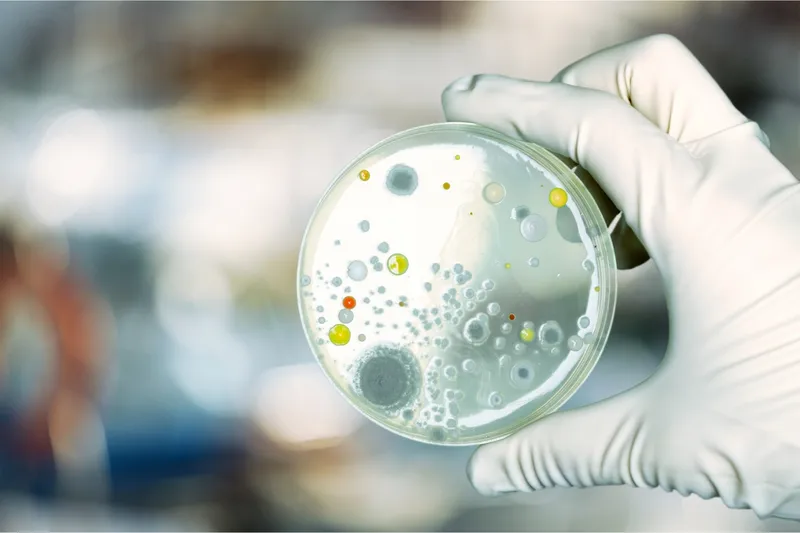

Au fost descoperiți 27 de microbi care cresc cu 250% riscul de cancer pancreatic. Trăiesc în gură
Cercetătorii au descoperit 27 de microbi, bacterii și fungi, care trăiesc în gura omului și cresc cu 250% riscul de cancer pancreatic. „Descoperirile noastre oferă noi perspective asupra relației dintre microbiomul oral și cancerul pancreatic”, a declarat șefa studiului.
O echipă formată din cercetători de la NYU Langone Health și de la Centrul de Cancer Perlmutter au prelevat probe de salivă de la 122.000 de bărbați și femei sănătoși din SUA, în cadrul unui studiu de prevenire a cancerului al Societății Americane de Cancer și al unui studiu de screening pentru cancerul de prostată, plămâni, colorectal și ovarian. Iar participanții au fost urmăriți în medie timp de nouă ani, orice înregistrări ale tumorilor fiind adăugate la date.
Citește și: Tot mai mulți tineri fac cancer de colon, pancreas, esofag și stomac. Care e explicația?
Au fost descoperiți 27 de microbi care cresc cu 250% riscul de cancer pancreatic. Trăiesc în gură
Din acest set vast de date, cercetătorii au identificat 445 de participanți care au fost în cele din urmă diagnosticați cu cancer pancreatic.
ADN-ul lor microbian a fost analizat și comparat cu alte 445 de persoane fără cancer, selectate aleatoriu în cadrul studiilor.
Apoi, cercetătorii au luat în considerare variabile precum vârsta, rasa și obiceiul de a fuma.
Ceea ce au descoperit a fost că 24 de specii de bacterii și fungi au crescut sau au redus riscul de cancer pancreatic. Iar acest lucru s-a adăugat la trei tipuri de bacterii care fuseseră deja implicate în dezvoltarea bolii parodontale, infecția care erodează țesutul gingival și osul din jurul dinților.
Persoanele cu combinația specifică de microbi problematici au avut un risc cu 250% mai mare de a dezvolta cancer pancreatic comparativ cu populația generală.
Citește și: Băuturile fierbinți cresc riscul de cancer esofagian. Oamenii de știință spun care e legătura
Relația dintre microbiomul oral și cancerul pancreatic
Acest studiu este primul care identifică o colecție de microbi specifici care contribuie la riscul de cancer, iar o ciupercă - un tip de drojdie din genul Candida care trăiește pe piele și în tot corpul - pare să joace un rol specific. Aceste specii orale de Candida au fost prezente și în țesutul tumorilor pancreatice ale pacienților.
„Descoperirile noastre oferă noi perspective asupra relației dintre microbiomul oral și cancerul pancreatic”, a declarat autoarea principală a studiului, Yixuan Meng, cercetător postdoctoral în cadrul Departamentului de Sănătate a Populației de la NYU Grossman School of Medicine, relatează newatlas.com.
Foto: Specii orale de Candida au fost prezente și în țesutul tumorilor pancreatice ale pacienților
Cancerul pancreatic, unul dintre cele mai mortale
Cancerul pancreatic poate să nu fie cel mai frecvent, dar este unul dintre cele mai mortale.
Societatea Americană de Cancer a constatat că doar 8% dintre persoanele diagnosticate cu această boală vor trăi mai mult de cinci ani - aceasta este cea mai mică rată de supraviețuire la cinci ani dintre cele peste 20 de tipuri de cancer comune.
Oamenii de știință au identificat anterior o legătură între microbiomul oral și cancerul pancreatic și au emis teoretizarea că anumite bacterii s-ar putea alătura salivei înghițite și ar putea călători către organ.
Ceea ce a descoperit această cercetare este un nou instrument puternic în diagnosticarea avansată a cancerului, care permite medicilor să intervină înainte de dezvoltarea tumorii, cu un tratament concentrat pe corectarea diversității și abundenței speciilor din microbiom.
În prezent, există foarte puține metode eficiente de screening care pot evalua riscul unor boli viitoare.
„Prin profilarea populațiilor bacteriene și fungice din gură, oncologii ar putea fi capabili să identifice persoanele care au cea mai mare nevoie de screening pentru cancerul pancreatic”, a declarat Jiyoung Ahn, co-autor principal al studiului, profesor la NYU Grossman School of Medicine.
Deși cercetarea stabilește doar o legătură între acești 27 de microbi și cancerul pancreatic, este cea mai cuprinzătoare înțelegere pe care o avem despre modul în care gura noastră contribuie la boli în alte părți ale corpului.
Sunt necesare mai multe cercetări pentru a descoperi ce mecanisme ar putea determina acest risc.
„Este mai clar ca niciodată că periajul și folosirea aței dentare nu numai că pot ajuta la prevenirea bolilor parodontale, ci pot și proteja împotriva cancerului”, a declarat Richard Hayes, co-autor principal al studiului, profesor în cadrul Departamentului de Sănătate a Populației.
În 2024, aceeași echipă de cercetători a făcut o altă descoperire, asociind anumite specii de microbiom oral cu un risc crescut de a dezvolta carcinom cu celule scuamoase la nivelul capului și gâtului – care își are originea în celulele care căptușesc suprafețele umede ale gurii, nasului și gâtului.
În continuare, vor analiza dacă virusurile orale agravează șansele de cancer și dacă anumiți microbi contribuie la șansele de supraviețuire ale persoanelor cu cancer pancreatic.
Constatările studiului fac acum parte dintr-un număr tot mai mare de dovezi care leagă igiena orală de probleme de sănătate în organism, inclusiv boala Alzheimer și afecțiuni mintale, inclusiv depresia.
Studiul a fost publicat în revista JAMA Oncology.